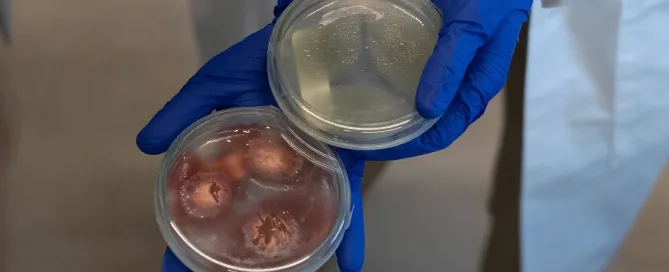
biodegradable

Innovation in Sustainable Packaging: Advances and the Future of Biodegradable Packaging
In a world where sustainability is a priority, the packaging industry is undergoing a crucial transformation. Technological advances in biodegradable packaging are leading the revolution, offering more responsible solutions aligned with the environmental demands of the present and the future.